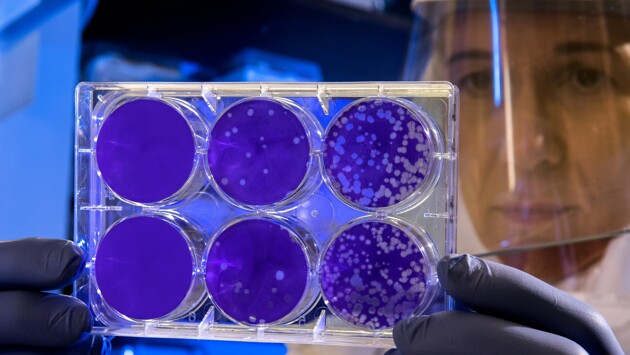

Ученые Квинслендского университета обнаружили новый вид генипавируса у землероек в штате Алабама, он получил название вирус Кэмп-Хилл.
«Анализ РНК тканей четырех пойманных северных короткохвостых землероек в штате Алабама выявил новый генипавирус, - говорится в статье. - Результаты исследования показывают наличие генипавирусных инфекций в Северной Америке», — отмечается в статье журнала Emerging Infectious Diseases.
В свою очередь в комментарии электронному журналу The Microbiologist один из авторов исследования Рис Пэрри сказал, что "обнаружение генипавируса в Северной Америке крайне важно, так как можно сделать вывод, что подобные вирусы распространены по миру шире, чем предполагалось ранее". Ученый подчеркнул, что для понимания может ли вирус передаваться от животных к человеку необходимы дополнительные исследования. По мнению исследователей, он схож с обнаруженным в Китае вирусом Ланье.
Заболевание, вызываемое генипавирусом может протекать как в бессимптомной форме, так и в виде тяжелой респираторной инфекции с летальным исходом. Считается, что естественный резервуар этих двух вирусов в дикой природе - летучие мыши.